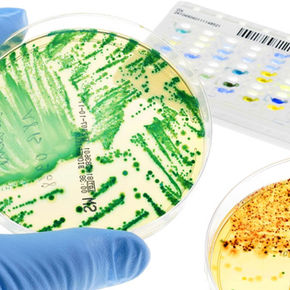
“Antibiotiques, la fin du miracle ?” : l’enquête choc d’Arte qui fait monter la fièvre

top of page
Notre forum


26 mars 20191 min de lecture


26 mars 20192 min de lecture


26 mars 20192 min de lecture


26 mars 20192 min de lecture

25 mars 20193 min de lecture


25 mars 20197 min de lecture


25 mars 20192 min de lecture


25 mars 20191 min de lecture


24 mars 20193 min de lecture


23 mars 20191 min de lecture


22 mars 20191 min de lecture


21 mars 20191 min de lecture


20 mars 20194 min de lecture


20 mars 20192 min de lecture


19 mars 20193 min de lecture


19 mars 20191 min de lecture


18 mars 20193 min de lecture


18 mars 20195 min de lecture


18 mars 20192 min de lecture


17 mars 20192 min de lecture


16 mars 20195 min de lecture


15 mars 20191 min de lecture


15 mars 20191 min de lecture


14 mars 20191 min de lecture
Démarrez une discussion
Soyez le premier à rédiger un post dans cette catégorie.
bottom of page

